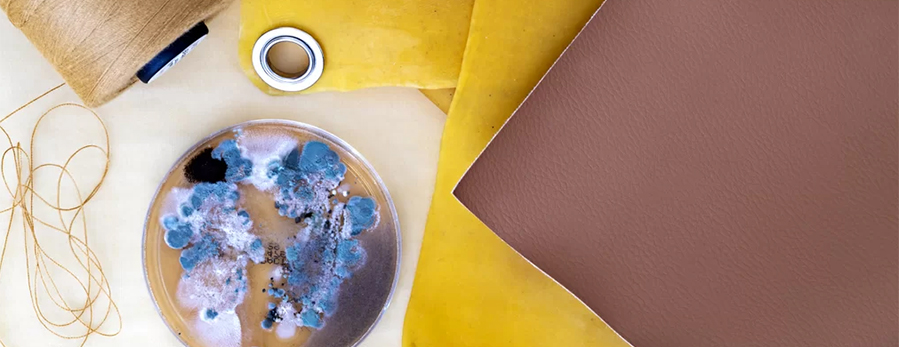

#HEIMTEXTIL 2024
Pioneering, interactive, fascinating: Heimtextil Trend Space 2024 brings the future to life
With the title “New Sensitivity”, the Heimtextil Trends 24/25 heralds a paradigm shift: away from trends as the driver towards transformation as the driving force. From 9 to 12 January 2024, trade visitors to Heimtextil will be able to experience what this means in real terms in the “Trend Space”. In addition to the relevant colour, theme and style worlds, the elaborately designed area in Hall 3.0 offers fascinating extras, including various networking and knowledge offers as well as interactive presentations on AI and AR.
Tour through Trend Space 2024
Experience more, discover more: “Trend Space” includes a total of four theme and trend worlds, a lecture area and various installations and material collections. The elaborate productions are largely implemented using the products of the Heimtextil exhibitors – this time the choice of materials is more sustainable than ever. In presentations, visitors can exchange ideas directly with international industry pioneers. In addition, the stations each convey one of the key colours of the 24/25 textile season.
Anyone going on tour with the audio guide in the “Heimtextil Navigator” starts in the “colour area”. The impressive staging illustrates the upcoming palette of trend shades and presents selected colouring processes from the companies Colorifix and Ever Dye in the workshop area.
The trend “technological textiles” develops the areas of upcycling and recycling as well as textile construction and design. At Variant 3D, visitors learn about pioneering 3D knitting technologies for a collaborative ecosystem. Following this trend world, they are immersed into the topics “walls & windows” and “bed & bath” whose contemporary design bridges the gap between decorative and functional aspects, innovation and well-being.
In the trend world of “bio-engineered textiles”, numerous exhibitor products and the companies Noosa, Pond Global and CiCLO will provide insights into how the fusion of plant-based and technical qualities is changing the way textiles are produced.
In the third trend “plant-based textiles” visitors experience the world of plant-based textile solutions. Companies such as Ettitude Materials, Desserto and Re-root tex Solution demonstrate live on site what is already possible in this field.
Between AI, AR and ASMR: tangible technology
In addition to the current trends and styles, “Trend Space” offers tangible presentations on technology highlights: The AI installation designed by the extended reality studio MANND and SPOTT trends & business lets visitors create their own AI-supported designs. At the neighbouring AR station, visitors can explore the augmented reality of Augmented Weaving. In her installation “Textile Thrills”, artist Olga Benedicte focuses on the topic of ASMR (autonomous sensory meridian response). Here, audiovisual and sensory effects make it possible to experience the thrill of textiles through the screen.
Material innovations: Fibre gallery and “Future Materials”
In collaboration with the technology stations, the Fibre gallery presents future compositions of textiles, including samples of the mycelium-based textile EPHEA developed by Mogu, textiles made from banana fibres from Bananatex, a bamboo-based leather alternative from Von Holzhausen and much more. The design consultancy FranklinTill curates its global showcase of cutting-edge textiles and materials. “Future Materials” is an integral part of “Trend Space”. The exhibition illustrates the principles of
Lecture program
Visitors will experience a real “Deep Dive” in the trend presentations by Anja Bisgaard Gaede, owner of SPOTT trends & business and lead of the Heimtextil Trends 24/25. The trend lectures take place twice a day, the guided tours once a day. In addition, the 2024 lecture program will impress with relevant topics and renowned experts, including Marta Giralt Dunjó (FranklinTill Studio) with her report on new materials, Anja Laursen and Bettina Lauridsen (NewRetex A/S) on AI solutions in recycling and Anne Marie Commandeur (stijlinstituut amsterdam) on the future of design.

















